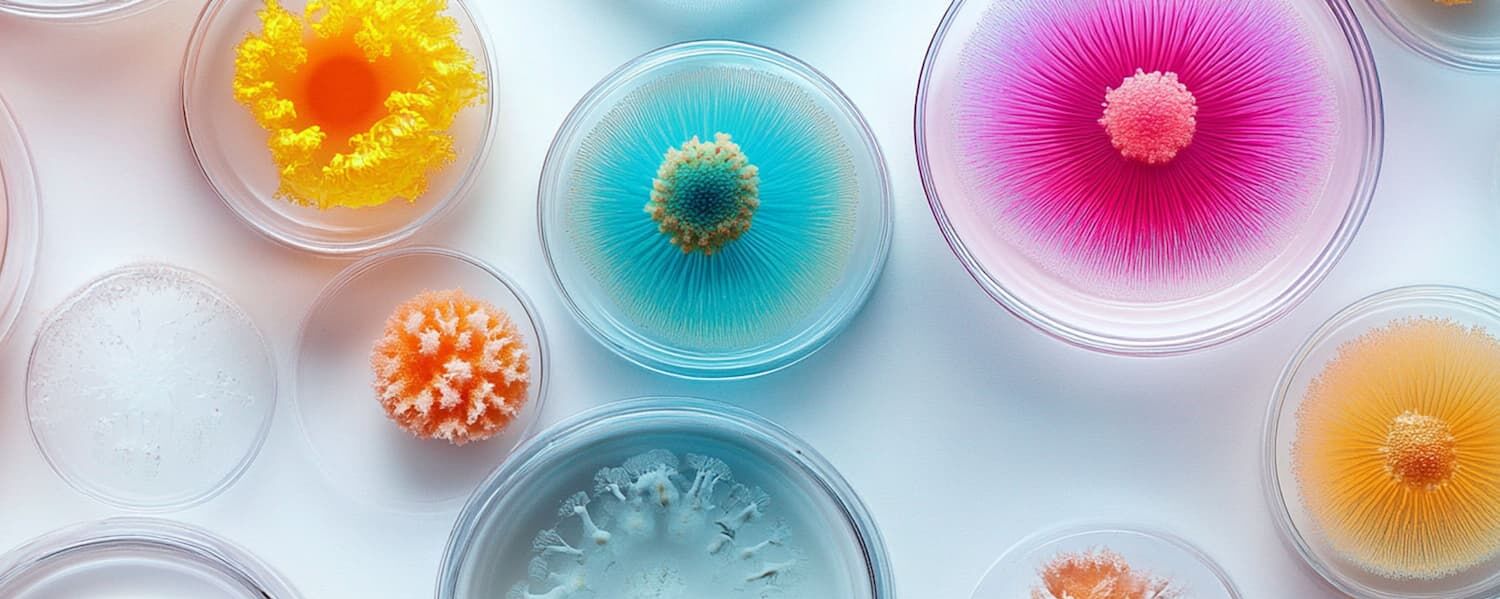
Materiały z grzybni Ephea zamiast skóry zwierząt

Materiały z grzybni Ephea zamiast skóry zwierząt
Mądra współpraca z naturą zamiast rabunkowej eksploatacji jej zasobów ponad miarę, to najlepszy i jedyny rozsądny trend dla cywilizacji nastawionej na przetrwanie. Surowce odnawialne w obiegu cyrkularnym są gwarancją nieskrępowanego rozwoju bez szkody dla środowiska naturalnego, którego jesteśmy częścią.
Eko trendy w modzie należą do roślin
Grzybnia Ephea do produkcji skór
Włoska firma biotechnologiczna SQIM z dumą podkreśla, że powstała nie po to, by eksploatować naturę, ale by z nią współpracować i diametralnie zmieniać sposób, w jaki powstają rzeczy, z korzyścią dla ludzi i planety. To symboliczna deklaracja inżynierii przyszłości i odnowy świata, który tak pochopnie popsuliśmy, ale wciąż jesteśmy w stanie naprawić. W laboratoriach SQIM powstają namacalne dowody nauki czerpanej wprost z natury, pionierskie rozwiązania z odnawialnego surowca, którego nigdy nie zabraknie - z mycelium czyli grzybni. Jednym z nich jest kolekcja innowacyjnych materiałów akustycznych z grzybni i biomasy Mogu. Kolejnym dowodem na sukces nauki w naśladowaniu natury jest Ephea, marka i nazwa produktów z powodzeniem zastępujących skórę w przemyśle modowym.
Materiał z grzybni Ephea produkowany w arkuszach
Ephea to materiał nowej generacji, biofabrykowany z grzybni i zaprojektowany, by na nowo zdefiniować relację między naturą, innowacją i designem, łączy w sobie wydajność techniczną, estetykę i zrównoważony rozwój. Skalowalność produkcji pozwala wytwarzać dokładnie tyle, ile potrzeba i łatwo jest się dostosować do aktualnego zapotrzebowania, wysoka wydajność liczona jest w tygodniach, nie w latach, jak to mam miejsce w przypadku skór zwierząt. W świecie do biomateriałów, zarówno niskoemisyjna producja, jak i bezproblemowa utylizacja nie przyczyniają się do degradacji środowiska. Przeciwnie ich obecność w łańcuchu dostaw oznacza znaczną redukcję zapotrzebowania na materiały pozyskiwane z hodowli zwierząt, co wpływa na odwrócenie niekorzystnego dla środowiska bilansu emisji gazów cieplarnianych.
Materiały z grzybni Ephea zamiast skóry zwierząt
Materiały Ephea zostały opracowane i zaprojektowane, aby mogły spełniać specyfikacje wymagane w takich kategoriach, jak wyroby skórzane, akcesoria oraz odzież, a ich funkcjonalność i wszechstronność zostały sprawdzone i potwierdzone w procesie produkcji produktów końcowych. W chwili obecnej materiał Ephea produkowany jest w arkuszach, a właściwości produktu końcowego mogą być zaprogramowane i osiągnięte w opatentowanej metodzie fermentacji. Współpraca z lokalnymi zakładami garbarskimi owocuje bogatą kolekcją faktur, kolorów i wariantów wykończenia. Alternatywa skóry Ephea może być w szerokim zakresie personalizowana, co już wykorzystują marki luksusowych produktów ze skóry do limitowanych kolekcji modowych.
Ephea to materiał nowej generacji, biofabrykowany z grzybni i zaprojektowany, by na nowo zdefiniować relację między naturą, innowacją i designem
Materiał Ephea narodził się w laboratorium kilka lat temu, a dziś jest produkowany w całkowicie ukończonym zakładzie pilotażowym i już trafia na rynek, a w przyszłym roku planowane jest otwarcie zakładu demonstracyjnego. Ephea jest uprawiana z grzybni w procesie regeneracyjnym, przy wykorzystaniu surowców o niskiej wartości i niskim zużyciu energii. Współpraca z naturą zobowiązuje i właściciel marki Ephea firma SQIM dowodzi, że można produkować zaawansowane technologicznie materiały nie szkodząc naturze. Proces produkcyjny Ephea radykalnie ogranicza zużycie wody i użytkowanie gruntów, a jednocześnie znacznie redukuje emisję CO₂ w porównaniu z materiałami konwencjonalnymi, takimi jak skóra zwierzęca. Nowatorska technologia SQIM zapowiada nową erę materiałów dla mody i nie tylko, a to dobrze wróży naszej wspólnej walce o lepszy klimat.
Materiału z grzybni marki Ephea na wybiegu Balenciagi.